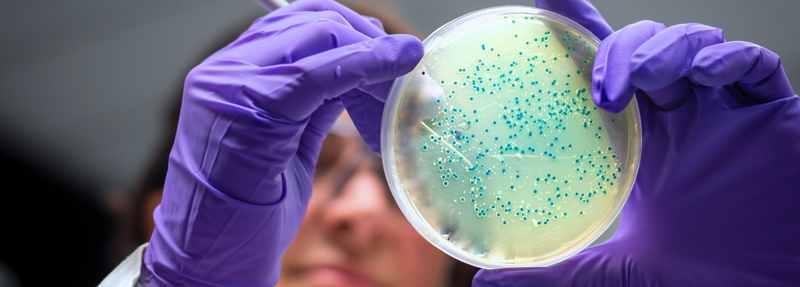

We are ready to assist and advise
If you have any questions about the product or you are interested in finding out how we can help you to develop, please use the telephone number below or email our sales department using the form below.
+45 75 50 80 00

From start to finish: How to buy cultures
To ensure that you get the right product, we follow a clear and structured process. We make sure that all the important details are in place from the start.
We start with your needs and go through step-by-step specifications, assess samples if needed and prepare an offer to ensure the right conditions for delivery - all to find the optimal solution for you.
Read the latest insights
Partners
We are ready to assist and advise
Call our sales department or fill in the form and we will get in touch.